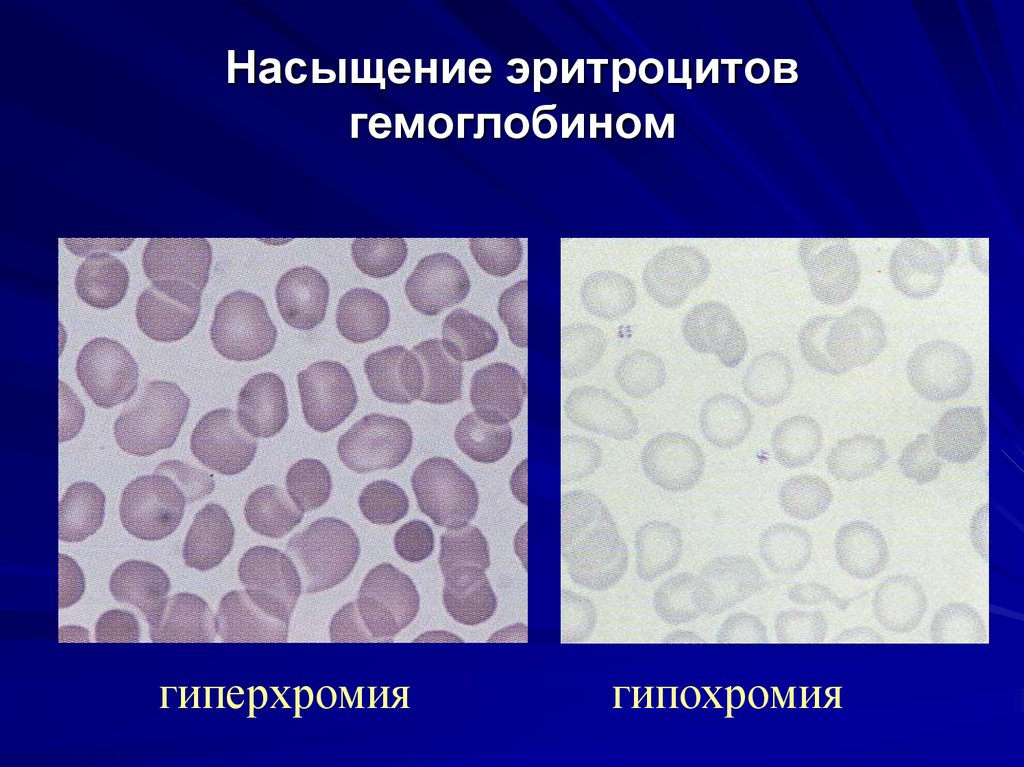
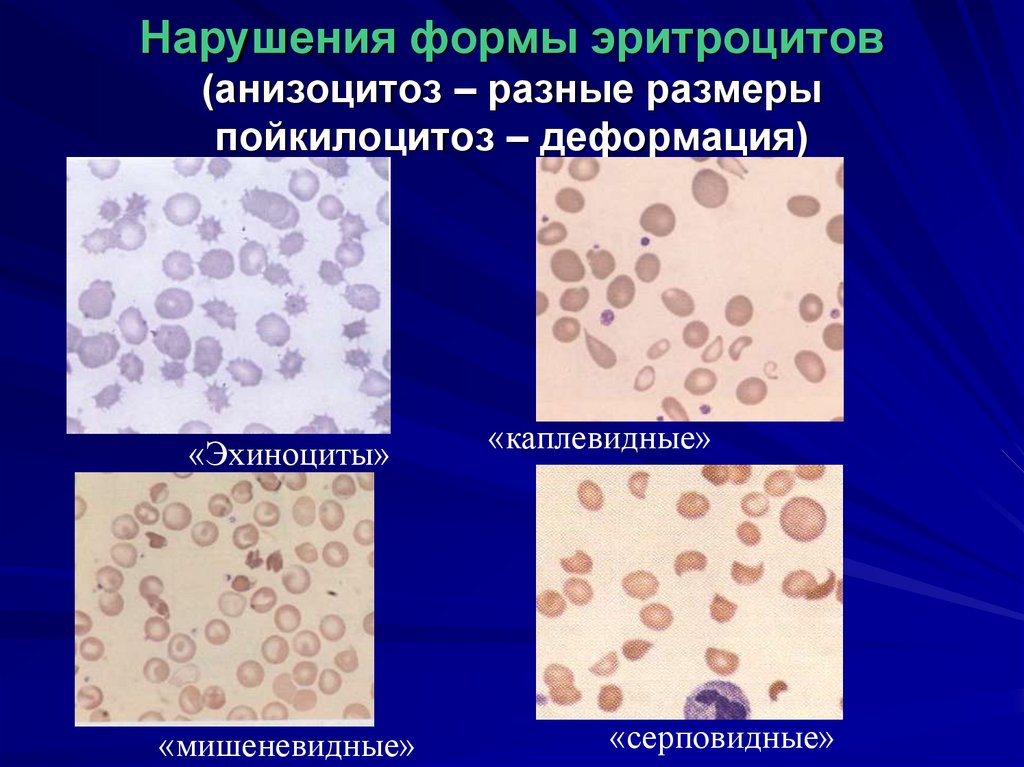
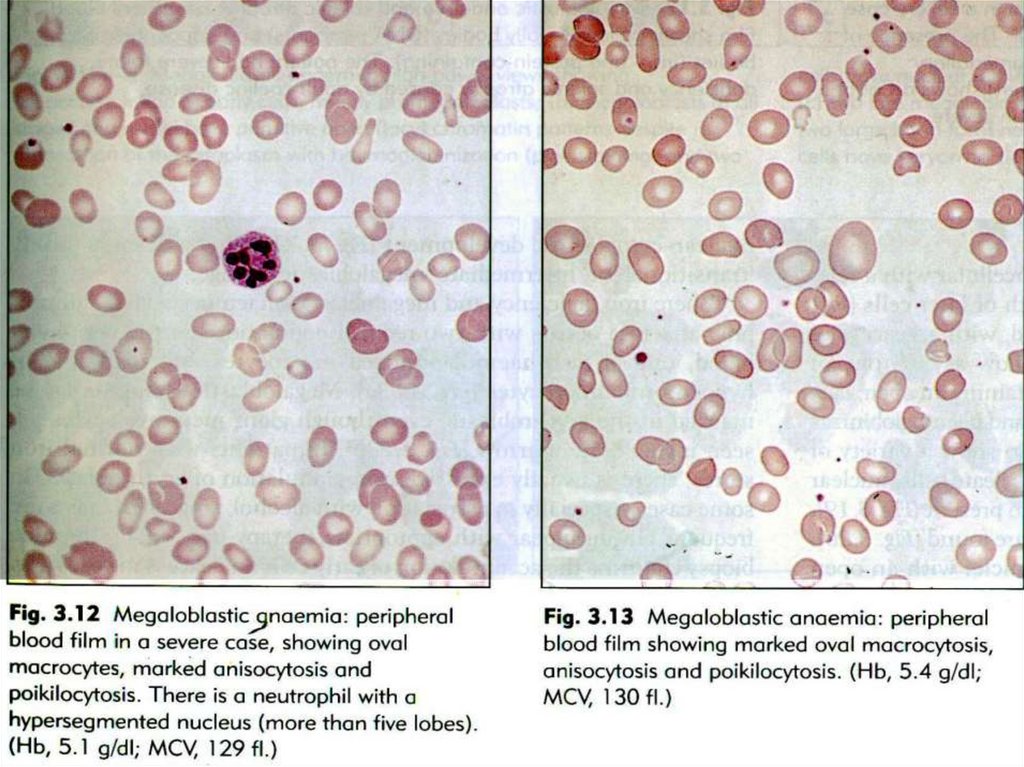
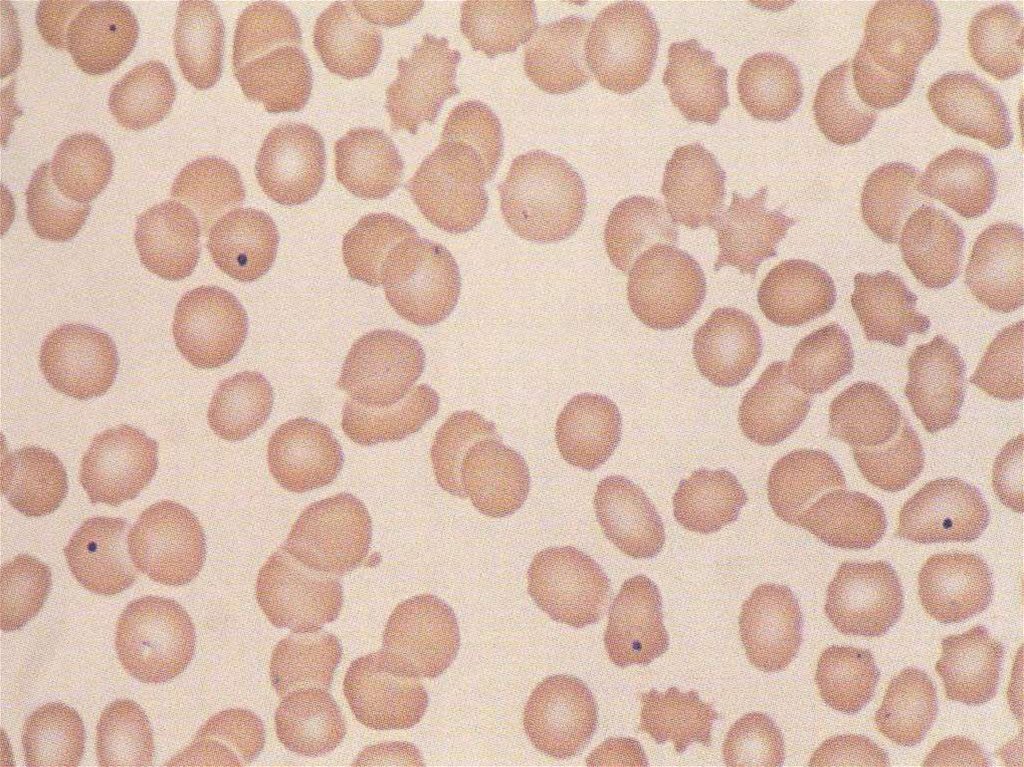

Similar presentations:
Семиотика анемий
1.
Семиотика анемийлекция для студентов III курса
А.С. Лямкина
к.м.н, кафедра терапии, гематологии и
трансфузиологии
2.
3.
Первичныелимфоидные
органы:
Органы кроветворения человека
Вторичные
лимфоидные
органы:
тимус
лимфоидная
ткань кольца
Вальдейера
костный
мозг
белая
пульпа
селезенки
лимфатические
узлы
лимфоидные
образования
слизистых
(Пейеровы
бляшки)
4.
Норма/патология эритроцитов:цветовой показатель = 3 х уровень Hb (гр)
первые три цифры Эр
-нормохромия
0,85-1,05
- гиперхромия
>1,05
-гипохромия
<0,85
размеры эритроцитов
Средний диаметр в норме
7-8 мкм
- микроцитоз 5,0-6,9 мкм
- макроцитоз > 8,0 мкм
5. ретикулоциты
6. Дополнительные параметры гемограммы
Гематологическийанализатор
Особенности технологических
зон мазка крови
7. Общий анализ крови:
8. Эритроциты
9.
ОБЩИЙ АНАЛИЗ КРОВИ (красная кровь)RBC – количество эритроцитов
HGB – концентрация гемоглобина
HCT - гематокрит
MCV – средний объем эритроцитов (80-100 фл) –
коррелирует со средним диаметром
MCH – среднее содержание гемоглобина в эритроците
(27-32 пг) – аналог цветового показателя
MCHC – средняя концентрация гемоглобина в
эритроците (300-380 г/л)
RDW-CV (%), RDW-SD – ширина распределения
эритроцитов по объему (11,5-14,5%) – показатель
анизоцитоза
10.
MCH – среднее содержаниегемоглобина в эритроците
(пг - пикограмм)
HGB г/л
RBC /л
норма=28-33 пг
11. MCV – средний объем эритроцита (фл - фемтолитр)
Гематокрит(%)*10кол-во ЭР /л
норма=80-96 фм
12. MCHC – средняя концентрация гемоглобина в 1 литре эритроцитов (г/л)
HGB г/л *10Гематокрит (%)
норма=320-340 г/л
13. RDW - ширина распределения эритроцитов по объему (%)
Средний диаметр ЭРСредний объем (MCV)
%
норма = до 14,5 %
m
14.
РетикулоцитыКоличество ретикулоцитов отражает скорость
продукции эритроцитов в костном мозге. Их подсчёт
имеет значение для оценки степени активности
эритропоэза.
Rt ‰ – 6,7 – 19,2 (мужчины), 5,9 – 20,7 (женщины)
Rt = 6-20 ‰
«ретикулоцитарный индекс»:
% ретикулоцитов х гематокрит больного / 45 х 1,85
(где: 45 — нормальный гематокрит, а 1,85 — количество
суток
необходимых
для
поступления
новых
ретикулоцитов
в
периферическую
кровь).
индекс < 2 — свидетельство гипопролиферативного
компонента анемии;
индекс > 2 - 3 — свидетельство увеличения образования
эритроцитов.
15.
Семиотика анемий16. Анемия – «бескровие» (an – без; haim – крови)
Под термином анемия понимаютпатологическое
состояние,
характеризующееся уменьшением
содержания
гемоглобина
или
количества эритроцитов в единице
объема крови.
17. Анемия
По этиопатогенетическому признаку анемии делятся(по И.А. Кассирскому, Г.А. Алексееву, 1970):
I группа:
Анемии вследствие острой и
хронической
кровопотери
(постгеморрагические)
18. Анемия
II группа: Анемии вследствие нарушениякровообразования (эритропоэза)
1. Железодефицитные
2. Сидероахрестические
3. В12 и фолиеводефицитные
4. Гипо-апластические
5. Миелодиспластические
6. Метапластические
19. Анемия
IIIгруппа:
Анемии
вследствие
повышенного
кроворазрушения
(гемолитические)
1. Наследственные
анемии
гемолитические
2. Приобретенные
анемии
гемолитические
20. Анемии классифицируются:
По цветовому показателю:Нормохромная 0,85 – 1,05 (MCH 27-33 pg)
Гипохромная < 0,85 (MCH менее 27 pg)
Гиперхромная > 1,05 (MCH более 33 pg)
21. Насыщение эритроцитов гемоглобином
гиперхромиягипохромия
22. Ретикулоциты крови
По уровню ретикулоцитов, свидетельствующемуоб активности эритропоэза, анемии
подразделятся на:
Норморегенераторные 5-10 ‰
Гиперрегенераторные ≥ 15 ‰
Гипорегенераторные < 5 ‰
Ретикулоциты крови
23. макроциты
Нарушения размеров эритроцитовмакроциты
микроциты
24. Нарушения формы эритроцитов (анизоцитоз – разные размеры пойкилоцитоз – деформация)
«Эхиноциты»«мишеневидные»
«каплевидные»
«серповидные»
25. Средний диаметр эритроцита
26.
По среднему диаметру и объемуэритроцитов:
Нормоцитарные = 7 – 7,5 (80-100
фл)
Микроцитарные < 7 (менее 80 фл)
Макроцитарные > 8 (более 100 фл)
Мегалоцитарные > 12-20
27.
Кривые Прайса-Джонса в норме (1),при ЖДА (2) и дефиците В12 и фолатов (3)
28.
Симптомы анемии:I. Анемический синдром неспецифические проявления
общеанемического состояния
- бледность кожных покровов и слизистых
- одышка, слабость
- головокружение , мелькание «мушек»
перед глазами
29. Клиника анемии:
бледность кожи и слизистыхСлизистые больного с анемией
Внешний вид больной
с анемией
30. Симптомы анемии:
II. Специфические проявления для данноготипа анемий:
- сидеропения (ломкость ногтей, сухость
кожи ) – при Fe-дефицитной анемии
31. Симптомы анемии:
II. Специфические проявления для данноготипа анемий:
- фуникулярный миелоз (парастезии,
нарушение чувствительности) - при
дефиците витамина B12
32. Симптомы анемии:
II. Специфические проявления для данноготипа анемий:
- желтуха при гемолитической анемии
III. Проявления основного заболевания
(причины анемии)
33. Основные критерии ЖДА 1. Гипохромия эритроцитов, микроцитоз.
34.
Основные критерии ЖДА2. Изменение показателей феррокинетики:
А) Снижение уровня сывороточного железа.
Б) Снижение коэффициента насыщения
трансферрина (КНТ).
В) Повышение общей железосвязывающей
способности сыворотки (ОЖСС).
Г) Снижение содержания ферритина в крови.
35. ЗНАЧЕНИЕ ЖЕЛЕЗА - Основная функция железа в организме -перенос кислорода и «хранение» его в крови, обеспечение кислородом мышц;
- железо связано с ферментами:цитохромами и железо-серными
белками - переносчик электронов,
катализатор реакций ОКСИГЕНАЦИИ,
ГИДРОКСИЛИРОВАНИЯ и других
жизненно важных метаболических
процессов.
36. ГИПОСИДЕРОЗ - тканевой ДЖ поражаются 1. кожа, ее придатки (волосы, ногти) и слизистые. 2. Желудочно-кишечный тракт 3. Нервная
система4. Сердечно-сосудистая система
37. СИДЕРОПЕНИЧЕСКИЙ СИНДРОМ: * дистрофические изменения кожи и слизистых, койлонихии, атрофия слизистой желудка, пищевода,
глоссит, гингивит, стоматит,дисфагия).
38.
СИДЕРОПЕНИЧЕСКИЙ СИНДРОМ:* извращение вкуса и обоняния (мел,
известь, земля, глина, сырое мясо,
сырое тесто, сырой картофель, запахи
– бензина, лако-красочных изделий);
* мышечные боли вследствие
дефицита миоглобина;
* мышечная гипотония (дизурия и
недержание мочи при кашле, смехе,
ночной энурез).
39.
сидеропеническийсиндром
-изменение
формы
за счет
истончения
ногтевой
пластинки
40. Сухость кожи, трещины в уголках губ
сидеропеническийсиндром
Сухость кожи, трещины в уголках губ
41.
42. В12 дефицитная анемия
1. Гиперхромная анемия2. Макроцитоз (d 9-10 мкм)
3. Анизо, пойкилоцитоз
43. В12 дефицитная анемия
1. Тельца Жолли, кольца Кебота2. Гиперсегментация нейтрофилов
3. Лейкопения, тромбоцитопения
4. Ретикулоциты – N или снижены
44.
45.
46. Клинические проявления
Поражение ЖКТПоражение кроветворной системы
Поражение нервной системы
(фуникулярный
миелоз)
–
парестезии,
шаткость
походки,
атаксия, снижение всех видов
чувствительности,
трофические
расстройства,
психические
расстройства, нарушение функции
тазовых органов, галлюцинации.
47.
48.
49.
50. АНЕМИИ ГЕМОЛИТИЧЕСКИЕ
•уменьшение продолжительности жизни Эр•КМ функционирует нормально – эритрон
КМ расширен
•увеличено количество ретикулоцитов в КМ
и в периферич. крови
•билирубин сыворотки крови
•положительная прямая и непрямая реакции
Кумбса (при аутоиммунном гемолизе)
51. Классическая триада гемолитических симптомов:
Анемия.Желтушность кожных покровов и
склер.
Спленомегалия.
+
Лихорадка, потемнение мочи (цвет
темного пива)
52.
АНЕМИИ ГЕМОЛИТИЧЕСКИЕ53.
54. АПЛАСТИЧЕСКАЯ АНЕМИЯ
ПАНЦИТОПЕНИЯЛейкопения
Анемия
Тромбоцитопения
55.
Синдром инфекционных осложнений:• Язвенно-некротический стоматит
• Язвенно-некротическая ангина
• Токсическая энтеропатия
• Бактериальные, грибковые, вирусные
инфекции

medicine
medicine








